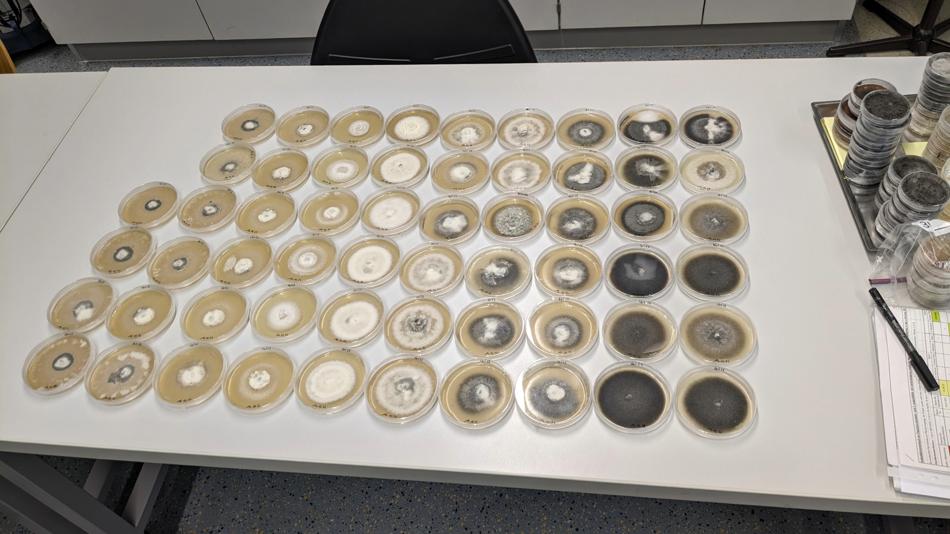
Zahlreiche runde Proben in Petrischalen ordentlich auf einem Tisch ausgelegt

Vortrag
Wer bedroht unseren Wald – und wie können wir ihn schützen?
Durchschnittliche Verweildauer: 80 Minuten
Dieses Vortragsprogramm wird an der Station angeboten:
18:00 - 18:45 "Ein Blick unter die Rinde - Borkenkäferforschung in Österreich" von Elisabeth Ritzer & Johannes Blümke
19:00 - 19:20 "Eschentriebsterben in unseren Wäldern: Wie funktioniert die Rettung einer Baumart? von Jasmin Barl
19:30 - 19:50 "Der Klimawandel begünstigt die Ausbreitung des Pinien-Prozessionsspinners in Österreichs" von Sonja Mader
20:00 - 20:20 "Pilze, Baumkrankheiten und Klimafitness unserer Wälder" von Pascal Rabl
20:30 - 20:50 "Kleine Käfer, großer Impact: Wie der Borkenkäfer in Zeiten des Klimawandels unsere Wälder verändern wird" von Till Hallas
21:00 - 21:20 "Verborgene Vielfalt: Paraditoide in heimischen Eichenwäldern" von Thomas Zankl
21:30 - 21:50 "Biologische Bekämpfung des hoch-invasiven Götterbaumes" von Benjamin Dauth
Besucherinformation
Anfahrtsbeschreibung: Sie erreichen den Standort Türkenschanze mit den öffentlichen Verkehrsmitteln: Bus 10A (Station: Dänenstraße) Bus 37A (Station: Dänenstraße) Bus 40A (Richtung Döblinger Friedhof Station: Dänenstraße, Richtung Schottentor Station: Dänenstraße) So kommen Sie mit dem 40A in 20 Minuten vom Schottentor, mit dem 37A Richtung Dänenstraße in 10 Minuten von der U-Bahn Station Spittelau zu uns an die Türkenschanze.
Dieser Ausstellungsstandort ist barrierefrei zugänglich und verfügt über barrierefreie Toiletten.
Öffnungszeiten
Information
Die maximale Teilnehmer:innenzahl für die Mitmachstation beträgt 2-3 Personen, für die Ausstellung 15 Personen und für die Vorträge 25 Personen.
18 weitere Stationen an diesem Standort
-
 Experiment / VorführungWas macht einen zukunftstauglichen Baustoff aus?Thema: Naturwissenschaften TechnikRessourcenschonende Baustoffe Recyclingbeton und Lehm: Bei dieser Station werden die Ausgangsstoffe für die Herstellung von Recyclingbeton und Lehmziegel vorgestellt. Darüber hinaus wird die zerstörende und zerstörungsfreie Prüfung ausgewählter fertiger (erhärteter) Baustoffe zur Veranschaulichung der wesentlichen Eigenschaften vorgeführt. Es wird auch die Möglichkeit zum Mitmachen geben.BOKU University17:00 - 23:00
Experiment / VorführungWas macht einen zukunftstauglichen Baustoff aus?Thema: Naturwissenschaften TechnikRessourcenschonende Baustoffe Recyclingbeton und Lehm: Bei dieser Station werden die Ausgangsstoffe für die Herstellung von Recyclingbeton und Lehmziegel vorgestellt. Darüber hinaus wird die zerstörende und zerstörungsfreie Prüfung ausgewählter fertiger (erhärteter) Baustoffe zur Veranschaulichung der wesentlichen Eigenschaften vorgeführt. Es wird auch die Möglichkeit zum Mitmachen geben.BOKU University17:00 - 23:00 -
 MitmachstationMaterialforschung - Warum bricht's?Thema: NaturwissenschaftenWissen Sie schon wie Knochen, Holz oder Turbinenstahl auf Belastung reagieren? An unserem Informationsstand stellen wir die Beziehung zwischen Struktur und Eigenschaften verschiedener Materialien vor. Welche Untersuchungsmethoden erlauben uns Einblick in die Materialien und deren Verhalten zu bekommen? Machen Sie mit uns einen Streifzug in die Welt der Materialwissenschaft an der BOKU!BOKU University17:00 - 22:00
MitmachstationMaterialforschung - Warum bricht's?Thema: NaturwissenschaftenWissen Sie schon wie Knochen, Holz oder Turbinenstahl auf Belastung reagieren? An unserem Informationsstand stellen wir die Beziehung zwischen Struktur und Eigenschaften verschiedener Materialien vor. Welche Untersuchungsmethoden erlauben uns Einblick in die Materialien und deren Verhalten zu bekommen? Machen Sie mit uns einen Streifzug in die Welt der Materialwissenschaft an der BOKU!BOKU University17:00 - 22:00 -
KinderprogrammWie vermittelt man Wissenschaft kindergerecht?Thema: GesellschaftBei dieser Station demonstrieren die Mitarbeiterinnen der KinderBOKU wie man wissenschaftliche Themen für Kinder aufbereiten kann. Die Besucher*innen im Kindergarten- und Volksschulalter erfahren mehr über die Forschungsfelder der BOKU über interaktive Plakate und kleine Bücher. Die Kinder erhalten ebenfalls eine Stempelkarte für weitere Stationen. Wenn sie alle Stempel gesammelt haben, wartet eine Belohnung.BOKU University16:00 - 19:55
-
 MitmachstationLandscape Innovation Lab: Sollte Landschaftsplanung ein Spiel sein?Thema: Digitalisierung NaturwissenschaftenWir sagen: Ja! Mit spielbasierten Ansätzen machen wir komplexe Zusammenhänge verständlich, senken Barrieren und ermöglichen Partizipation auf Augenhöhe. Entdecken Sie, wie 3D Game-Design und Virtual Reality komplexe Entscheidungen greifbar machen – vom Ausbau erneuerbarer Energien bis zur Renaturierung.BOKU University16:00 - 23:00
MitmachstationLandscape Innovation Lab: Sollte Landschaftsplanung ein Spiel sein?Thema: Digitalisierung NaturwissenschaftenWir sagen: Ja! Mit spielbasierten Ansätzen machen wir komplexe Zusammenhänge verständlich, senken Barrieren und ermöglichen Partizipation auf Augenhöhe. Entdecken Sie, wie 3D Game-Design und Virtual Reality komplexe Entscheidungen greifbar machen – vom Ausbau erneuerbarer Energien bis zur Renaturierung.BOKU University16:00 - 23:00 -
 AusstellungWas können verschiedene Baustoffe und Konstruktionsweisen in modernen Bauwerken leisten - und welchen Umwelteinfluss haben sie dabei?Thema: TechnikUnsere Gebäude müssen heute mehr können als nur Schutz bieten: Sie sollen CO2 speichern, Energie sparen und Generationen überdauern. Doch welche Rolle spielen unterschiedliche Baustoffe dabei? Wir zeigen Ihnen den Vergleich zwischen bewährten Materialien und neuen Ansätzen. Erleben Sie die faszinierenden Eigenschaften stabiler Mauern und ökologischer Tragwerken. Diskutieren Sie mit uns, womit wir morgen bauen.BOKU University16:00 - 22:30
AusstellungWas können verschiedene Baustoffe und Konstruktionsweisen in modernen Bauwerken leisten - und welchen Umwelteinfluss haben sie dabei?Thema: TechnikUnsere Gebäude müssen heute mehr können als nur Schutz bieten: Sie sollen CO2 speichern, Energie sparen und Generationen überdauern. Doch welche Rolle spielen unterschiedliche Baustoffe dabei? Wir zeigen Ihnen den Vergleich zwischen bewährten Materialien und neuen Ansätzen. Erleben Sie die faszinierenden Eigenschaften stabiler Mauern und ökologischer Tragwerken. Diskutieren Sie mit uns, womit wir morgen bauen.BOKU University16:00 - 22:30 -
 MitmachstationHow can landslides be investigated from an applied geological view?Thema: NaturwissenschaftenThis station tries to bring the topic of landslide research closer to the public. The station is split into 3 parts: firstly, looking on the bigger scale of remote sensing and the use of monitoring devices for alpine landslide research; secondly, investigating specific landslide study cases around the world showing soil samples and thirdly: showing related laboratory works about grain size analyses.BOKU University16:00 - 22:00
MitmachstationHow can landslides be investigated from an applied geological view?Thema: NaturwissenschaftenThis station tries to bring the topic of landslide research closer to the public. The station is split into 3 parts: firstly, looking on the bigger scale of remote sensing and the use of monitoring devices for alpine landslide research; secondly, investigating specific landslide study cases around the world showing soil samples and thirdly: showing related laboratory works about grain size analyses.BOKU University16:00 - 22:00 -
 MitmachstationWie können grün-blaue Infrastrukturen zum Regenwassermanagement beitragen?Thema: Technik UmweltRegenwassermanagement erlaubt es, Niederschläge möglichst vollständig in den natürlichen Wasserkreislauf zurückzugeben und vor Ort zur Verfügung zu stellen. Dieser Beitrag soll zeigen, wie anfallendes Regenwasser mit grün-blauen Infrastrukturen versickert, gespeichert und verdunstet werden kann. Dies wird in interaktiven Stationen für die Besucherinnen und Besucher erlebbar gemacht.BOKU University16:00 - 23:00
MitmachstationWie können grün-blaue Infrastrukturen zum Regenwassermanagement beitragen?Thema: Technik UmweltRegenwassermanagement erlaubt es, Niederschläge möglichst vollständig in den natürlichen Wasserkreislauf zurückzugeben und vor Ort zur Verfügung zu stellen. Dieser Beitrag soll zeigen, wie anfallendes Regenwasser mit grün-blauen Infrastrukturen versickert, gespeichert und verdunstet werden kann. Dies wird in interaktiven Stationen für die Besucherinnen und Besucher erlebbar gemacht.BOKU University16:00 - 23:00 -
 MitmachstationWelche Maßnahmen muss ein Reaktorfahrer in Zaporizhzhia ergreifen, um den Reaktor bei einem Störfall in einen sicheren Zustand zu bringen?Thema: GesellschaftAtomkraftwerke spielen in der Diskussion über klimaneutrale Energiequellen eine große Rolle. Die Gefahr, die von ihnen ausgeht, wird bei einem Atomkraftwerksunfall wie Fukushima deutlich. Sie haben bei uns die Möglichkeit, in die Rolle einer Kraftwerksfahrerin bzw. eines Kraftwerksfahrers zu schlüpfen – wie würden Sie bei einem Unfall handeln?BOKU University16:00 - 22:00
MitmachstationWelche Maßnahmen muss ein Reaktorfahrer in Zaporizhzhia ergreifen, um den Reaktor bei einem Störfall in einen sicheren Zustand zu bringen?Thema: GesellschaftAtomkraftwerke spielen in der Diskussion über klimaneutrale Energiequellen eine große Rolle. Die Gefahr, die von ihnen ausgeht, wird bei einem Atomkraftwerksunfall wie Fukushima deutlich. Sie haben bei uns die Möglichkeit, in die Rolle einer Kraftwerksfahrerin bzw. eines Kraftwerksfahrers zu schlüpfen – wie würden Sie bei einem Unfall handeln?BOKU University16:00 - 22:00 -
 Experiment / VorführungWie schützt man sich vor radioaktiver Strahlung?Thema: GesellschaftDas Institut für Sichterheits- und Risikowissenschaften informiert über radioaktive Strahlung und zeigt praxisnahe Schutzmaßnahmen sowie Messgeräte. Vieles kann ausprobiert werden, etwa ein schwerer Schutzanzug. Zudem werden aktuelle Themen beleuchtet, beispielsweise geschlechtsspezifische Unterschiede in der Wirkung von Strahlung.BOKU University16:00 - 23:00
Experiment / VorführungWie schützt man sich vor radioaktiver Strahlung?Thema: GesellschaftDas Institut für Sichterheits- und Risikowissenschaften informiert über radioaktive Strahlung und zeigt praxisnahe Schutzmaßnahmen sowie Messgeräte. Vieles kann ausprobiert werden, etwa ein schwerer Schutzanzug. Zudem werden aktuelle Themen beleuchtet, beispielsweise geschlechtsspezifische Unterschiede in der Wirkung von Strahlung.BOKU University16:00 - 23:00 -
 Experiment / VorführungWelche Gefahren birgt Mikroplastik?Thema: Gesundheit TechnikDiese Station macht mit den Risiken und Quellen von Mikroplastik vertraut.BOKU University16:00 - 23:00
Experiment / VorführungWelche Gefahren birgt Mikroplastik?Thema: Gesundheit TechnikDiese Station macht mit den Risiken und Quellen von Mikroplastik vertraut.BOKU University16:00 - 23:00 -
 Experiment / VorführungDo-It-Yourself Kleinwindkraft – eine Technologie mit Zukunft?Thema: EnergieDerzeit sind in Österreich 1450 Windkraftanlagen im Betrieb. Neben diesen Großanlagen gibt es auch Kleinwindkraftanlage mit wenigen Kilowatt Leistung, die teilweise im Eigenbau hergestellt werden können. Das Institut für Sicherheits- und Risikowissenschaften stellt Techniken vor; Potentiale und Herausforderungen werden diskutiert. Ein selbstgebautes Kleinwindrad mit 3D-gedruckten Rotorblättern kann besichtigt werden.BOKU University16:00 - 23:00
Experiment / VorführungDo-It-Yourself Kleinwindkraft – eine Technologie mit Zukunft?Thema: EnergieDerzeit sind in Österreich 1450 Windkraftanlagen im Betrieb. Neben diesen Großanlagen gibt es auch Kleinwindkraftanlage mit wenigen Kilowatt Leistung, die teilweise im Eigenbau hergestellt werden können. Das Institut für Sicherheits- und Risikowissenschaften stellt Techniken vor; Potentiale und Herausforderungen werden diskutiert. Ein selbstgebautes Kleinwindrad mit 3D-gedruckten Rotorblättern kann besichtigt werden.BOKU University16:00 - 23:00 -
 MitmachstationKönnen wir den Boden mit KI klassifizieren?Thema: Digitalisierung NaturwissenschaftenMithilfe einer speziellen entwickelten Box kann die Kornverteilung des Bodens durch ein KI-Modell abgeschätzt werden. Das Modell funktioniert mit Smartphone-Bildern, die über eine Web-Applikation hochgeladen werden. Die Besucherinnen und Besucher können selbst die Kornverteilung unterschiedlicher Bodenarten mit ihren Handy prognostizieren.BOKU University19:00 - 21:45
MitmachstationKönnen wir den Boden mit KI klassifizieren?Thema: Digitalisierung NaturwissenschaftenMithilfe einer speziellen entwickelten Box kann die Kornverteilung des Bodens durch ein KI-Modell abgeschätzt werden. Das Modell funktioniert mit Smartphone-Bildern, die über eine Web-Applikation hochgeladen werden. Die Besucherinnen und Besucher können selbst die Kornverteilung unterschiedlicher Bodenarten mit ihren Handy prognostizieren.BOKU University19:00 - 21:45 -
 AusstellungHow do cyclists and pedestrians interact with each other in a shared road with dedicated cycle lanes?Thema: Digitalisierung EnergieThis VR exhibition presents an interactive and scientifically grounded simulation of cyclist–pedestrian interactions on shared roads with dedicated cycle lanes. Using a VR headset and bike simulator, visitors actively experience typical traffic situations and conflict scenarios. The installation translates research into an immersive format, raising awareness for safe, evidence-based urban street design.BOKU University16:00 - 23:00
AusstellungHow do cyclists and pedestrians interact with each other in a shared road with dedicated cycle lanes?Thema: Digitalisierung EnergieThis VR exhibition presents an interactive and scientifically grounded simulation of cyclist–pedestrian interactions on shared roads with dedicated cycle lanes. Using a VR headset and bike simulator, visitors actively experience typical traffic situations and conflict scenarios. The installation translates research into an immersive format, raising awareness for safe, evidence-based urban street design.BOKU University16:00 - 23:00 -
WorkshopWie gestalten wir unsere Energiezukunft?Thema: EnergieWelcher Zusammenhang besteht zwischen Energieverbrauch, Energieversorgung und Raumstrukturen? Wieviel Energie wird in Ihrer Gemeinde verbraucht und wieviel CO2 wird dabei ausgestoßen? Wie groß sind die Flächen, die für eine erneuerbare Energieversorgung erforderlich sind? Finden Sie in einem Planspiel eine erneuerbare Energielösung für die Beispiel-Region.BOKU University17:00 - 23:00
-
 MitmachstationAlt und verstaubt? No way! Was "können" historische Sammlungen?Thema: KulturSammeln übt auf viele Menschen aller Altersgruppen große Faszination aus. Zu beliebten Sammlungsobjekten gehören Sticker, Steine und Schneckenhäuser. Doch was ist mit den Sammlungen vergangener Jahrhunderte? Anhand von zwei Beispielen stellen wir historische Sammlungen der BOKU vor. Dabei können Sie selbst die Übersetzung alter Schriften ausprobieren oder über moderne Analysemethoden lernen.BOKU University16:00 - 21:50
MitmachstationAlt und verstaubt? No way! Was "können" historische Sammlungen?Thema: KulturSammeln übt auf viele Menschen aller Altersgruppen große Faszination aus. Zu beliebten Sammlungsobjekten gehören Sticker, Steine und Schneckenhäuser. Doch was ist mit den Sammlungen vergangener Jahrhunderte? Anhand von zwei Beispielen stellen wir historische Sammlungen der BOKU vor. Dabei können Sie selbst die Übersetzung alter Schriften ausprobieren oder über moderne Analysemethoden lernen.BOKU University16:00 - 21:50 -
 KinderprogrammWie fördern Wald- und Naturkindergruppen die unfallfreie Bewegung und das Spielen in der Natur der Klein- und Vorschulkinder?Thema: Gesellschaft UmweltUnsere Station gibt Einblick in aktuelle Forschungsergebnisse zu Wald- und Naturkindergruppen. Wir präsentieren Poster von Studierenden, die sich mit Wald- und Naturpädagogik, Wirtschaftlichkeit, Infrastruktur und Marketing auseinandersetzen. Sie erleben durch interaktive Spiele, wie Kinder unfallfrei mit Naturmaterialien umgehen und hierdurch ihre geistige und motorische Entwicklung fördern sowie Gesundheit stärken.BOKU University16:00 - 20:00
KinderprogrammWie fördern Wald- und Naturkindergruppen die unfallfreie Bewegung und das Spielen in der Natur der Klein- und Vorschulkinder?Thema: Gesellschaft UmweltUnsere Station gibt Einblick in aktuelle Forschungsergebnisse zu Wald- und Naturkindergruppen. Wir präsentieren Poster von Studierenden, die sich mit Wald- und Naturpädagogik, Wirtschaftlichkeit, Infrastruktur und Marketing auseinandersetzen. Sie erleben durch interaktive Spiele, wie Kinder unfallfrei mit Naturmaterialien umgehen und hierdurch ihre geistige und motorische Entwicklung fördern sowie Gesundheit stärken.BOKU University16:00 - 20:00 -
 WorkshopWas und wen bewegt die Universität in der Region im Bereich Nachhaltigkeit?Thema: UmweltVeränderungen hin zu Nachhaltigkeit passieren nicht nur auf globaler Ebene, sondern vor allem vor Ort. Durch die Erzeugung und Weitergabe von Wissen, spielen Universitäten darin eine wichtige Rolle. Wir begehen Beispiele, wo und wie Universitäten im und für ihr räumliches Umfeld wirken. An verschiedenen Stationen halten Fachpersonen kurze Vorträge und bieten den Teilnehmenden Raum für Fragen und Austausch.BOKU University16:50 - 17:10 (Anmeldung erforderlich)
WorkshopWas und wen bewegt die Universität in der Region im Bereich Nachhaltigkeit?Thema: UmweltVeränderungen hin zu Nachhaltigkeit passieren nicht nur auf globaler Ebene, sondern vor allem vor Ort. Durch die Erzeugung und Weitergabe von Wissen, spielen Universitäten darin eine wichtige Rolle. Wir begehen Beispiele, wo und wie Universitäten im und für ihr räumliches Umfeld wirken. An verschiedenen Stationen halten Fachpersonen kurze Vorträge und bieten den Teilnehmenden Raum für Fragen und Austausch.BOKU University16:50 - 17:10 (Anmeldung erforderlich) -
 MitmachstationKann Thermografie nachts verborgene Mikrohabitate in der städtischen Natur Wiens sichtbar machen?Thema: Naturwissenschaften UmweltErleben Sie den Türkenschanzpark nach Sonnenuntergang: Mit der Wärmebildkamera machen wir verborgene Mikrohabitate sichtbar, von Baumkronen über Beete bis zu Ufern und Totholz. Entdecken Sie, wo Wärme gespeichert wird, wo sie entweicht und wie daraus Rückzugsorte oder Stresszonen für Insekten, Vögel, Fledermäuse und Bodenorganismen entstehen.BOKU University21:00 - 22:30 (Anmeldung erforderlich)
MitmachstationKann Thermografie nachts verborgene Mikrohabitate in der städtischen Natur Wiens sichtbar machen?Thema: Naturwissenschaften UmweltErleben Sie den Türkenschanzpark nach Sonnenuntergang: Mit der Wärmebildkamera machen wir verborgene Mikrohabitate sichtbar, von Baumkronen über Beete bis zu Ufern und Totholz. Entdecken Sie, wo Wärme gespeichert wird, wo sie entweicht und wie daraus Rückzugsorte oder Stresszonen für Insekten, Vögel, Fledermäuse und Bodenorganismen entstehen.BOKU University21:00 - 22:30 (Anmeldung erforderlich)